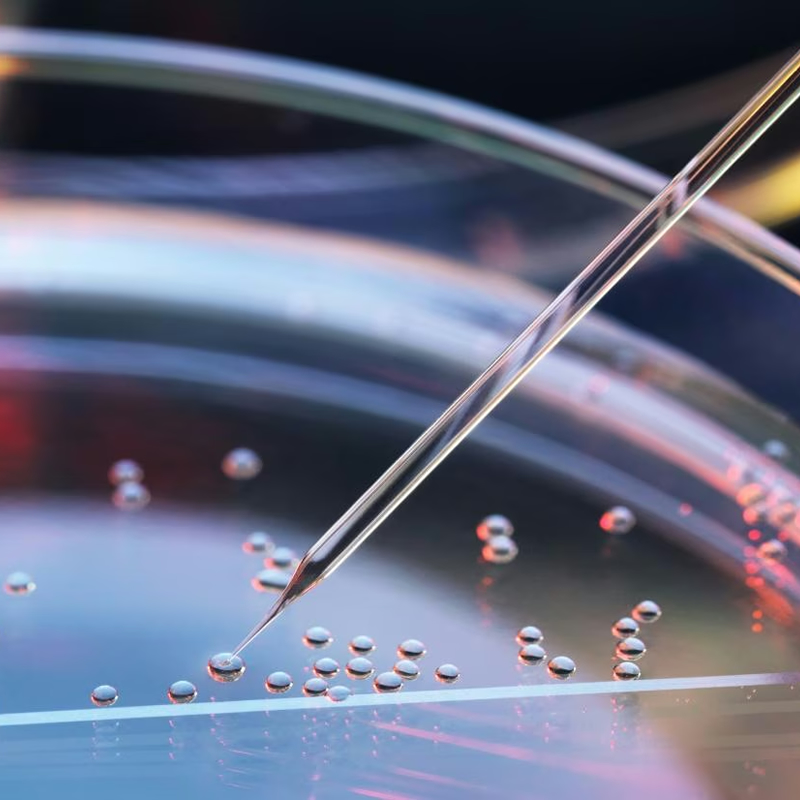
GRAFTING  AND REACTIVE RECYCLING

About Us
Who We Are
With over 20 years of expertise in the plastics industry, our consultancy firm specializes in providing cutting-edge solutions for the cable industry. We are pioneers in developing high-performance plastic compounds, offering customized services tailored to meet the unique needs of our clients.
Our Vision
We aim to revolutionize the plastic compounding sector by delivering innovative, sustainable, and high-value solutions that drive progress in the cable and related industries.
Leadership
Our Team, is a highly respected ...
Our Services
Blog / Announcements
21
January
Ensuring Excellence in Solar Cable Manufacturing
Key Material Properties, Extrusion Conditions, and Quality Standards
21
January
XLPE and XL-HFFR
Comparison of Tin-Based and Ambient Curing Catalyst Systems in Sioplas ...
21
January